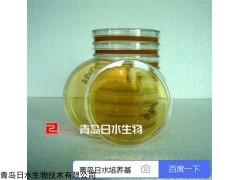

产品简介
胰酪大豆胨琼脂培养基TSA日水生物,培养基平板的价格,配方,使用方法,生产厂家等信息。
公司简介
微生物培养基|培养基的配方|培养基研发销售平台|干粉培养基|一次性接触皿平板青岛日水生物是微生物检测培养基研发、生产和销售的国家高薪技术企业。成立于2010年,是目前国内产品种类齐全的微生物培养基生产厂家。
作为国内国产专业微生物培养基口碑好,品质好,服务好,信誉好,质量好的实惠销售平台,公司致力于打造中国较好的培养基品牌和生产企业。公司包括研发部、质量控制与检验部、生产部、仓储部、销售部和办公生活区,实现从研发到生产销售一体的培养基现货供应服务商!
公司产品广泛应用于国家检验检疫机构、食品、制药、环境监测、水质检测、科研等领域;为微生物检验提供全面的解决方案,可灵活定制干粉培养基,以较大化满足客户的不同需求。
2018年公司致力于打造中国专业的培养基生产供应商!争做国内口碑好的微生物培养基专业品牌商!引领行内 制造企业和服务商!
产品系列:2015版药典干粉培养基、固体培养基、液体培养基、显色培养基、一次性无菌表面培养皿平板、表面接触碟、生化鉴定管,质控菌株等。
青岛日水生物详见网站
展开
产品说明
【32724P-1】
胰酪大豆胨琼脂培养基TSA日水生物
2015版《中国药典》培养基
内容物20~25毫升/个,90毫米×10个/包
三层真空包装

胰酪胨15克;大豆木瓜蛋白酶水解物5克;氯化钠5克;琼脂15克;蒸馏水1000毫升;pH7.3±0.2(25摄氏度)
胰酪大豆胨琼脂培养基TSA日水生物
2-25摄氏度避光保存
180天
产品来自:青岛日水培养基
胰酪大豆胨琼脂培养基TSA日水生物
沙氏葡萄糖琼脂培养基SDA
胰酪大豆胨液体培养基TSB
R2A琼脂培养基
麦康凯液体培养基
pH7.0氯化钠-蛋白胨缓冲液
本页产品地址:http://www.geilan.com/sell/show-9005347.html

免责声明:以上所展示的[
32724P-1 胰酪大豆胨琼脂培养基TSA日水生物]信息由会员[
青岛日水生物技术有限公司]自行提供,内容的真实性、准确性和合法性由发布会员负责。
[给览网]对此不承担任何责任。
友情提醒:为规避购买风险,建议您在购买相关产品前务必确认供应商资质及产品质量!

![]()

 免责声明:以上所展示的[32724P-1 胰酪大豆胨琼脂培养基TSA日水生物]信息由会员[青岛日水生物技术有限公司]自行提供,内容的真实性、准确性和合法性由发布会员负责。
免责声明:以上所展示的[32724P-1 胰酪大豆胨琼脂培养基TSA日水生物]信息由会员[青岛日水生物技术有限公司]自行提供,内容的真实性、准确性和合法性由发布会员负责。